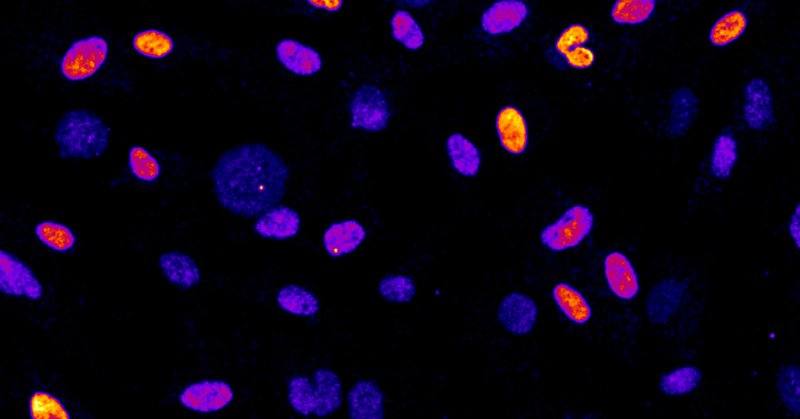
Tweet card summary image

Franz Meitinger
@Meitinger
Followers
377
Following
474
Media
29
Statuses
206
Assistant Professor interested in Mitosis, Genome Stability, Cancer and Centrosomes
Onna, Okinawa
Joined April 2011
Very happy to see our paper “Cancer-associated USP28 missense mutations disrupt 53BP1 interaction and p53 stabilization” featured in the @NatureComms Editors’ Highlights (Cancer). Many thanks to the editors for highlighting our work. https://t.co/naUqEO6V4g
0
2
5
Our study on the mitotic stopwatch is out. We demonstrate that USP28 interacts with 53BP1 to stabilize p53 and show that cancer cells frequently harbor mutations that impair stopwatch assembly, thereby suppressing the mitotic stress response. https://t.co/p4O1z8dea8
nature.com
Nature Communications - USP28 and 53BP1 proteins form a complex to stabilise the tumour suppressor p53, which is required to protect cells from mitotic stress and subsequent genome instability....
1
7
29
Congratulations to Hamzah for receiving the EMBO Molecular Medicine Poster Prize at #MBSJ2026. Well deserved! https://t.co/XoPOepBTZm
aeplan.jp
0
0
5
We’re recruiting a Postdoctoral Researcher at @OISTedu (Okinawa, Japan) to explore how mitotic stress shapes aging. If you’re excited about cell biology, aging, and mechanistic discovery, we’d love to hear from you. More info: https://t.co/lEdRcYbnGA
0
3
5
Join us for the #CellDivision2026 meeting in Okinawa. Abstract Submission Deadline: Nov 3. https://t.co/uyklm01xC9
0
4
4
Join us for the Cell Division Meeting in the Pacific Island setting of Okinawa. Hosted at OIST, this symposium brings together leading researchers to explore emerging roles of the cell cycle in development, cancer, and aging. Registration now open: https://t.co/ATGg9TYEjN
0
7
12
Excited to share our new preprint on @biorxivpreprint! We show that USP28 mutations found in cancer block its interaction with 53BP1, disrupting p53 stabilization. Check out the full story... https://t.co/t7XbfY3cID
1
8
24
Check out our review on "PLK4: Master Regulator of Centriole Duplication and Its Therapeutic Potential". Everything you need to know about centriole duplication, mitotic stopwatch and TRIM37-mediated cancer-specific vulnerabilities. @Midori_RuruOta
https://t.co/tm0BWhauuj
onlinelibrary.wiley.com
Centrosomes catalyze the assembly of a microtubule-based bipolar spindle, essential for the precise chromosome segregation during cell division. At the center of this process lies Polo-Like Kinase 4...
1
3
20
For all cell biologists: join the conference organized to celebrate 50 years of German Society for Cell Biology! https://t.co/FMSFjoRNxq Registration is open! See you in Heidelberg. #DGZ50
0
3
12
A prolonged mitosis is characteristic of defects that drive genome instability. What are the underlying causes and broader implications of prolonged mitosis? Check out our review... https://t.co/yFjjnyUKhG
0
5
20
Interested in Base Editing and Genetic Screening? Check out our method chapter: https://t.co/zeCQIETlSV Esther Ng did an excellent job developing these methods in our lab. The constructs will soon be available on @Addgene Many thanks to @OISTedu for supporting open access!
link.springer.com
Genetic engineering and screening in human cells are powerful techniques for the precise and comprehensive identification and analysis of gene and protein domain functions. Genome-wide knockout...
0
4
10
We are happy to share our review on the 53BP1-mediated activation of the tumor suppressor p53. We summarize the cell cycle-depend functions of 53BP1 during mitosis and interphase and address its role in maintaining a healthy tissue. https://t.co/sA1ZkYjGAP
0
8
34
We are looking for faculties interested in #Energy and #Sustainability broadly defined.
oist.jp
2
20
41
Big thanks to all @DKW_2024 participants for excellent science, engaging conversations, and mountain excursions! We hope to see everyone in Oxford in 2027. Thanks also to our generous sponsors @EMBOevents @Co_Biologists @eLife @Chromosoma_EB @snsf_ch @UNIGEnews @EMBO
1
19
49
Our paper "Control of cell proliferation by memories of mitosis" is out @ScienceMagazine. We show that cells can detect and memorize defects in mitosis to eliminate potentially damaged cells. @OISTedu @Meitinger @oegemadesai_lab
science.org
A study reveals how cells measure time spent in mitosis and relay that information to daughter cells.
7
57
201
🔬Groundbreaking research by OIST Cell Proliferation and Gene Editing Unit and collaborators show how cells become ultimate protectors against cancer!🧬Did you know cells sense defects by measuring the duration of #mitosis? @MeitingerOhta @oegemadesai_lab
oist.jp
A protein complex formed during abnormal cell division eliminates potentially harmful cells over time.
0
12
23
Our new paper is out in #NatureAging ! Cell membrane damage induces senescence! 1st authors --> @kouchocolate @OIST_KonoLab @apple_hani
https://t.co/jFQHJmzJdN
7
32
122
分からない病気は、治すことができません。 @MeitingerOhta’s Unitでは、細胞分裂はどのように正しく行われるのか、うまくいかなかった場合は何が起こるのかを研究。#がん の新たな治療 標的を探しています。#NewFacultyOfOIST @Meitinger @Midori_RuruOta 記事はこちらから⬇️
oist.jp
細胞増殖・ゲノム編集ユニットでは、細胞がどのように分裂し、何が原因で細胞内の病気が引き起こされるのかを研究し、がんの新たな治療標的を模索しています。
1
13
46